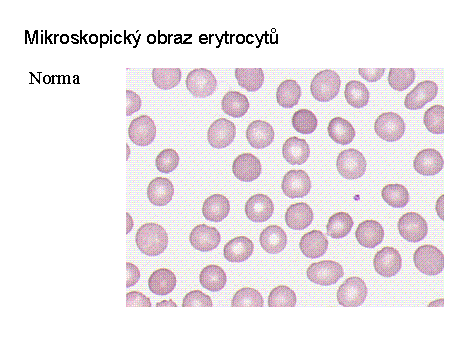

Abstrakt
Červené krvinky (erytrocyty) jsou krevní buňky. Vznikají v kostní
dřeni. Nemají jádro, přesto intenzivně metabolizují. Jejich hlavní funkcí
v organizmu je přenos kyslíku z plic do tkání a oxidu uhličitého
opačným směrem. Tuto funkci zprostředkovává hemoglobin. Průměr erytrocytu je
7,2 µm a má tzv. bikonkávní tvar. Životnost v organismu se pohybuje mezi
110-120 dny.
Odkazy na jiné relevantní dokumenty, další informace
Popis zralých periferních krevních buněk
Anomálie
erytrocytů
Literatura
Marshall, P. N., Bentley,
S. A., Lewis, S. M.: Staining properties and stability of a standardized
Romanowsky stain. Journal of Clinical Pathology 31, 1978, s. 280.
Autorské poznámky
Ilona Fátorová, Eva Fenclová